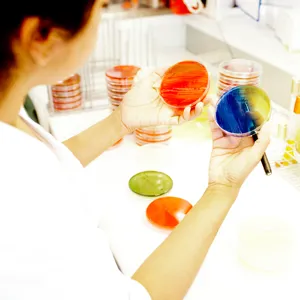
En person som holder et reagensrør

Antibiotikaresistens – forskningsgruppe
Hva forsker vi på?
Våre hovedsatsningsområder er antibiotikaresistens hos bakteriene Haemophilus influenzae og Bacteroides fragilis, herunder klinisk betydning, årsaker, mekanismer, forekomst, spredning, forebygging og reversering av resistens. Et sentralt område er utvikling og forbedring av laboratoriemetoder for påvisning av resistens, for å sikre virksom antibiotikabehandling ved bakterielle infeksjoner. Vi deltar også i kliniske prosjekter med fokus på rasjonell antibiotikabruk, behandling av urinveisinfeksjoner, og håndtering av multiresistente bakterier av særlig smittevernmessig betydning.
WHO har erklært at antibiotikaresistens truer selve kjernen av moderne medisin. I Norge er ett av målene i Regjeringens strategi mot antibiotikaresistens å frembringe «økt kunnskap om hva som driver utvikling og spredning av antibiotikaresistens». I tråd med dette er det overordnede formålet med forskningsgruppen å bidra til å bevare virksomme antibiotika for fremtidige generasjoner gjennom forskning på ulike aspekter av antibiotikaresistens. Dette representerer en stor nytteverdi for befolkningen i form av redusert sykelighet og dødelighet ved bakterielle infeksjoner. I tillegg er virksomme antibiotika en nødvendig forutsetning for blant annet avansert kreftbehandling, operasjoner og transplantasjoner.
Bakterien Haemophilus influenzae er en vanlig årsak til infeksjoner i ører, øyne, bihuler og luftveier, og den viktigste årsaken til symptomforverring hos KOLS-pasienter. Den kan også gi alvorlig lungebetennelse, blodforgiftning og hjernehinnebetennelse. Alvorlig sykdom med H. influenzae type b (Hib) hos barn ble sjelden etter innføring av Hib-vaksine i barnevaksinasjonsprogrammet i 1992, men fremdeles får rundt 100 mennesker blodbaneinfeksjon med H. influenzae hvert år i Norge.
Bakterien en svært viktig årsak til antibiotikabehandling i alle aldersgrupper, både i og utenfor sykehus. Tradisjonelt ble infeksjoner med H. influenzae behandlet med penicilliner, men siden 1970-tallet har mange stammer blitt resistente mot denne gruppen antibiotika. Siden 2000 har det blitt vanligere med resistens mot intravenøse antibiotika som brukes ved alvorlige infeksjoner. Dette kan være farlig ved for eksempel hjernehinnebetennelse, hvor rask behandling med et virksomt antibiotikum er avgjørende for utfallet.
Bakterien ble først beskrevet av Richard Pfeiffer under en influensapandemi i 1892. Slektsnavnet Haemophilus (”blod-elsker”) gjenspeiler at bakterien trenger stoffer som finnes i blod for å vokse. Artsnavnet influenzae fikk den fordi Pfeiffer feilaktig trodde at den var årsaken til influensa.
Bacteroides fragilis er en anaerob bakterie, det vil si at den vokser i fravær av oksygen. Bakterien inngår i menneskets normale tarmflora, og kan gi infeksjoner som for eksempel sårinfeksjoner etter kirurgi, abscesser i indre organer og blodforgiftning. Vi ser på forekomst og spredning av gener som bidrar til resistens mot antibiotika som brukes til behandling av alvorlige infeksjoner i sykehus, hvordan varierende uttrykk av genene påvirker resistens, og hvordan man med nye metoder enklest kan påvise disse resistensmekanismene i mikrobiologiske laboratorier.
Presentasjon av gruppen
Gruppen springer ut fra mikrobiologisk avdeling og ledes av overlege PhD Dagfinn Skaare. Forskningsgruppen har en tverrfaglig sammensetning hvor medlemmene har komplementær og høyspesialisert kompetanse innen en rekke disipliner, fra klassisk dyrkningsbasert bakteriologi til moderne genteknologiske metoder og avanserte bioinformatiske analyser. Tilgang til sekvenseringsinstrumenter og annen essensiell forskningsinfrastruktur, lang erfaring og et bredt nasjonalt og internasjonalt nettverk gjør oss i stand til å utføre resistensforskning på et høyt internasjonalt nivå ved Sykehuset i Vestfold.
The overriding goal of the AMR Research Group at Department of Microbiology, Vestfold Hospital Trust is ‘to preserve effective antibiotics for future generations’. Our main research fields are antimicrobial resistance in Haemophilus influenzae and Bacteroides fragilis, with particular focus on molecular mechanisms, regulation, development, dissemination, prevention, reversal, and detection of resistance. We are also engaged in projects addressing rational antibiotic usage, treatment of urinary tract infections, and nosocomial spread of multidrug-resistant bacteria such as ESBL and VRE.
For more information, please contact group leader MD PhD Dagfinn Skaare (dagfinn.skaare@siv.no).

Dagfinn Skaare (forskningsgruppeleder)
MD PhD
Postdoc / overlege, mikrobiologisk avdeling og smittevernseksjonen, Sykehuset i Vestfold
E-post: dagfinn.skaare@siv.no
Telefon: 920 86 350
Profil på ResearchGate

Nils Grude
MD PhD
Tidligere overlege, forsknings- og innovasjonsenheten, Sykehuset i Vestfold
E-post: nils-gr@online.no
Telefon: 404 07 563

Thor-Henrik Henriksen
MD PhD
Tidligere overlege, mikrobiologisk avdeling, Sykehuset i Vestfold
E-post: thorhh@sf-nett.no
Telefon: 952 41 718
Profil på ResearchGate

Helene Johannessen Wefring
Molekylærbiolog PhD
Postdoc, mikrobiologisk avdeling, Sykehuset i Vestfold
E-post: helene.johannessen@siv.no
Telefon: 979 60 181
Profil på ResearchGate
Inger Lill Anthonisen
Molekylærbiolog PhD
Molekylærbiolog/forsker, mikrobiologisk avdeling, Sykehuset i Vestfold
E-post: inger.anthonisen@siv.no
Telefon: 920 49 023
Profil på ResearchGate

Tore Taksdal Stubhaug
MD PhD-student (Universitetet i Oslo)
Overlege, mikrobiologisk avdeling, Sykehuset i Vestfold
E-post: tore.taksdal.stubhaug@siv.no
Telefon: 33 34 10 76

Nermin Zecic
MSc
Bioinformatiker, mikrobiologisk avdeling, Sykehuset i Vestfold
E-post: nermin.zecic@siv.no
Telefon: 473 85 739
Profil på ResearchGate

Kanita Pimpaporn
MSc
Bioingeniør, mikrobiologisk avdeling, Sørlandet sykehus
E-post: kanbue@sshf.no
Telefon: 980 93 218

Ann Kristin Berg
Fagbioingeniør, Mikrobiologisk avdeling, Sykehuset i Vestfold
E-post: annka@siv.no
Telefon: 411 05 341

Silje Rebekka Heltveit-Olsen
MD PhD-student (Universitetet i Oslo)
Lege kat D spesialist, Mikrobiologisk avdeling, Sykehuset i Vestfold
Epost: silje.rebekka.heltveit-olsen@siv.no
Telefon: 33 34 10 14

Ola Bjørang
Molekylærbiolog MSc
Molekylærbiolog/forsker, mikrobiologisk avdeling, Sykehuset i Vestfold
E-post: ola.bjorang@siv.no
Telefon: 900 76 508

Brukerrepresentant
Solvei Arheim
Brukerrepresentant, Sykehuset i Vestfold
Epost: Rut.Solvei.Arheim@siv.no
Telefon: 959 15 171
Improving antibiotic stewardship in hospitals using electronic records, individual feedback to prescribers, and assessing environmental risk of antibiotics in wastewater
Prosjektleder: Kirsten Midttun Gravningen, Akershus universitetssykehus
Counterattacking antibiotic resistance in Haemophilus influenzae: Molecular epidemiology of Integrative and Conjugative Elements and identification of conjugation inhibitors
Prosjektleder: Helene Johannessen, Sykehuset i Vestfold
Evolution and spread of high-level beta-lactam resistance in Haemophilus influenzae
Prosjektleder: Dagfinn Skaare, Sykehuset i Vestfold
Delprosjekter:
- Cefotaxime-resistant Haemophilus influenzae in Norway 2006-2018: Antimicrobial susceptibility profiles, resistance mechanisms and molecular epidemiology
- The fitness cost of penicillin-binding protein 3-mediated beta-lactam resistance in Haemophilus influenzae
A multifaceted approach to multidrug resistance in Haemophilus influenzae: exploring novel resistance mechanisms & making old antibiotics great again
Prosjektleder: Dagfinn Skaare, Sykehuset i Vestfold
Delprosjekter:
- Penicillin-binding protein 2-mediated beta-lactam resistance in Haemophilus influenzae
- Novel transferable non-beta-lactam resistance in Haemophilus influenzae (Prosjektleder: Helene Johannessen, PhD)
- The role of integrative conjugative elements in the spread of antibiotic resistance in Haemophilus influenzae (Prosjektleder: Helene Johannessen, PhD)
- Anti-bacterial and anti-biofilm effects of the alginate oligomer OligoG on Haemophilus influenzae. Kommentar: Master- og forskerlinjeprosjekt for Kaja Marienborg
Carbapenem resistance in Bacteroides fragilis – epidemiology, molecular mechanisms and phenotypic testing
Prosjektleder: Dagfinn Skaare MD PhD
Delprosjekter:
- Diagnostic methods for phenotypic detection of carbapenem resistance in Bacteroides
- Epidemiology of carbapenem-resistant invasive Bacteroides fragilis infections
- Experimental study to identify the mechanisms involved in the emergence of clinically significant MBL expression in Bacteroides fragilis strains possessing a silent cfiA gene
Treatment of pyelonephritis and urosepsis with pivmecillinam (MePUR)
Prosjektleder: Overlege PhD Tore Stenstad, infeksjonsmedisinsk seksjon, Sykehuset i Vestfold
A 1-yr program for tracking spread of antimicrobial resistance (ESBL/ESBLCARBA) in Yekatit 12 Hospital Medical College – The SAMRY study
Prosjektleder: Thor-Henrik Henriksen, MD PhD
Improving rational prescribing for UTI in frail elderly (ImpresU)
Prosjektleder: Morten Lindbæk MD PhD, Universitetet i Oslo
Antibakteriell effekt av urin etter administrasjon av aronia-juice – et forstudium
Prosjektleder: Tonje Holte Stea, Universitetet i Agder
2025
- Genomic profiling of cefotaxime-resistant Haemophilus influenzae from Norway and Sweden reveals extensive expansion of virulent multidrug-resistant international clones. Skaare D, Anthonisen IL, Zecic N, Jenkins A, Caugant DA, Ranheim TE, Sundsfjord A, Hegstad K, and Study Group on Exceptional Phenotypes in Haemophilus influenzae. Front Microbiol 2025 Jul 29;16: 1601390. doi: 10.3389/fmicb.2025.1601390.
- Methenamine hippurate as prophylaxis for recurrent urinary tract infections in older women—a triple-blind, randomised, placebo-controlled, phase IV trial (ImpresU). Heltveit-Olsen SR, Arnljots ES, Sundvall PD, Gunnarsson R, Kowalczyk A, Godycki-Cwirko M, Platteel TN, Groen WG, Lithén SS, Sundvall S, Åhrén C, Grude N, Verheij TJM, Hertogh CMPM, Lindbæk M, Høye S. Clin Microbiol Infect. 2025 Jul 14:S1198-743X(25)00344-1. doi: 10.1016/j.cmi.2025.07.006.
- Survey and control of antimicrobial resistance: need for pragmatic options in low-resource settings. Gissa SB, Zewdie SD, Kindie AD, Mugoro BT, Henriksen TH. Lancet Microbe. 2025 Mar;6(3):101021. doi: 10.1016/j.lanmic.2024.101021.
2024:
-
Gut microbiota patterns associated with duration of diarrhea in children under five years of age in Ethiopia. Tesfaw G, Siraj DS, Abdissa A, Jakobsen RR, Johansen ØH, Zangenberg M, Hanevik K, Mekonnen Z, Langeland N, Bjørang O, Safdar N, Mapes AC, Kates A, Krych L, Castro-Mejía JL, Nielsen DS. Nat Commun. 2024 Sep 2;15(1):7532. doi: 10.1038/s41467-024-51464-w.
-
Evaluation of NTRK expression and fusions in a large cohort of early-stage lung cancer. Dyrbekk APH, Warsame AA, Suhrke P, Ludahl MO, Zecic N, Moe JO, Lund-Iversen M, Brustugun OT. Clin Exp Med. 2024 Jan 19;24(1):10. doi: 10.1007/s10238-023-01273-0.
2023:
- Prevalence and assemblage of Giardia duodenalis in a case-control study of children under 5 years from Jimma, Southwest Ethiopia. Alemu Y, Abdissa A, Mekonnen Z, Sharew B, Johansen ØH, Bjørang O, Langeland N, Hanevik K, Moyo SJ; CRYPTO-POC study group. Parasitol Res. 2023 Dec 13;123(1):38. doi: 10.1007/s00436-023-08029-5.
- Upregulation of the cfiA carbapenemase gene in a Bacteroides fragilis strain by the novel integrative and conjugative element Tn7563. Stubhaug TT, Zecic N, Skaare D. Anaerobe. 2023 ;83:102785. doi: 10.1016/j.anaerobe.2023.102785. Epub 2023 Sep 23.
- Antimicrobial susceptibility testing of Bacteroides species by disk diffusion: The NordicAST Bacteroides study. Stubhaug TT, Giske CG, Justesen US, Kahlmeter G, Matuschek E, Sundsfjord A, Skaare D; Nordic Bacteroides AST Study Group. Anaerobe. 2023 Jun;81:102743. doi: 10.1016/j.anaerobe.2023.102743. Epub 2023 May 28.
- Measuring broad-spectrum antibiotic use in hospitals with established versus new indicators. Skaare D, Hannisdal A, Kalager M, Berild D.Tidsskr Nor Laegeforen. 2023 Apr 24;143(6). doi: 10.4045/tidsskr.22.0427. Print 2023 Apr 25.
- The alginate polymer OligoG alters susceptibility of biofilm-embedded non-typeable Haemophilus influenzae to ampicillin and ciprofloxacin. Marienborg K, Ambur OH, Økstad OAL, Skaare D.JAC Antimicrob Resist. 2023 Apr 18;5(2):dlad046. doi: 10.1093/jacamr/dlad046. eCollection 2023 Apr.
2022:
- The neglected importance of high-endemic ESBL sites. Henriksen TH, Getachew Y, Kindie AD, Mugoro BT, Zewdie SD, Tewabe E, Mihret W, Gissa SB. JAC Antimicrob Resist. 2022 Nov 3;4(6):dlac114. doi: 10.1093/jacamr/dlac114. eCollection 2022 Dec.
- Methenamine hippurate to prevent recurrent urinary tract infections in older women: protocol for a randomised, placebo-controlled trial (ImpresU). Heltveit-Olsen SR, Sundvall PD, Gunnarsson R, Snaebjörnsson Arnljots E, Kowalczyk A, Godycki-Cwirko M, Platteel TN, Koning HAM, Groen WG, Åhrén C, Grude N, Verheij TJM, Hertogh CMPM, Lindbaek M, Hoye S. BMJ Open. 2022 Nov 1;12(11):e065217. doi: 10.1136/bmjopen-2022-065217.
- Oocyst Shedding Dynamics in Children with Cryptosporidiosis: a Prospective Clinical Case Series in Ethiopia. Johansen ØH, Abdissa A, Bjørang O, Zangenberg M, Sharew B, Alemu Y, Moyo S, Mekonnen Z, Langeland N, Robertson LJ, Hanevik K. Microbiol Spectr. 2022 Aug 31;10(4):e0274121. doi: 10.1128/spectrum.02741-21. Epub 2022 Jun 14.
- Molecular epidemiology and antibiotic resistance profiles of invasive Haemophilus influenzae from Norway 2017–2021. Tønnessen R, García I, Debech N, Lindstrøm JC, Wester AL, Skaare D. Front Microbiol 2022;13:973257. doi: 10.3389/fmicb.2022.973257
- Characterization and Fitness Cost of Tn7100, a Novel Integrative and Conjugative Element Conferring Multidrug Resistance in Haemophilus influenzae.Johannessen H, Anthonisen IL, Zecic N, Hegstad K, Ranheim TE, Skaare D. Front Microbiol 2022;13:945411. doi: 10.3389/fmicb.2022.945411.
- Case Report: Whole-Genome Sequencing of Serially Collected Haemophilus influenzae From a Patient With Common Variable Immunodeficiency Reveals Within-Host Evolution of Resistance to Trimethoprim-Sulfamethoxazole and Azithromycin After Prolonged Treatment With These Antibiotics. Lindemann PC, Mylvaganam H, Oppegaard O, Anthonisen IL, Zecic N, Skaare D. Front Cell Infect Microbiol 2022;12:896823. doi: 10.3389/fcimb.2022.896823.
- An immunosuppressed woman in her sixties with a high fever. Marvik Å, Gudkov P, Grude N, Skudal H. Tidsskr Nor Laegeforen. 2022 Jun 2;142(10). doi: 10.4045/tidsskr.22.0060. Print 2022 Jun 28.
- The efficacy of pivmecillinam in oral step-down treatment in hospitalised patients with E. coli bacteremic urinary tract infection; a single-arm, uncontrolled treatment study. Hansen BÅ, Grude N, Lindbæk M, Stenstad T. BMC Infect Dis. 2022 May 19;22(1):478. doi: 10.1186/s12879-022-07463-7.
- Investigating the human jejunal microbiota. Villmones HC, Svanevik M, Ulvestad E, Stenstad T, Anthonisen IL, Nygaard RM, Dyrhovden R, Kommedal Ø. Sci Rep. 2022 Jan 31;12(1):1682. doi: 10.1038/s41598-022-05723-9.
2021:
- Performance and operational feasibility of two diagnostic tests for cryptosporidiosis in children (CRYPTO-POC): a clinical, prospective, diagnostic accuracy study. Johansen ØH, Abdissa A, Zangenberg M, Mekonnen Z, Eshetu B, Bjørang O, Alemu Y, Sharew B, Langeland N, Robertson LJ, Hanevik K. Lancet Infect Dis. 2021 May;21(5):722-730. doi: 10.1016/S1473-3099(20)30556-9. Epub 2020 Dec 3.
- Development of a EUCAST disk diffusion method for the susceptibility testing of rapidly growing anaerobic bacteria using Fastidious Anaerobe Agar (FAA) - Development study using Bacteroides species. Bavelaar H, Justesen US, Morris TE, Anderson B, Copsey-Mawer B, Stubhaug TT, Kahlmeter G, Matuschek E. Clin Microbiol Infect. 2021 Nov;27(11):1695.e1-1695.e6. doi: 10.1016/j.cmi.2021.03.028. Epub 2021 Apr 2.
- Low prevalence of tick-borne encephalitis virus antibodies in Norwegian blood donors. Marvik Å, Tveten Y, Pedersen AB, Stiasny K, Andreassen ÅK, Grude N. Infect Dis (Lond). 2021 Jan;53(1):44-51.
2020:
- Loss of smell or taste as the only symptom of COVID-19. Hjelmesæth J, Skaare D. Tidsskr Nor Laegeforen. 2020 Apr 3;140(7). doi: 10.4045/tidsskr.20.0287. Print 2020 May 5.
- Role of Horizontal Gene Transfer in the Development of Multidrug Resistance in Haemophilus influenzae. Hegstad K, Mylvaganam H, Janice J, Josefsen E, Sivertsen A, Skaare D. mSphere. 2020 Jan 29;5(1):e00969-19.
- Predicting the use of antibiotics after initial symptomatic treatment of an uncomplicated urinary tract infection: analyses performed after a randomised controlled trial. Vik I, Mdala I, Bollestad M, Cordoba GC, Bjerrum L, Neumark T, Damsgaard E, Bærheim A, Grude N, Lindbaek M. BMJ Open. 2020 Aug 30;10(8):e035074.
- Microbial risk factors for treatment failure of pivmecillinam in community‐acquired urinary tract infections caused by ESBL‐producing Escherichia coli. Syre H, Hetland MAK, Bernhoff E, Bollestad M, Grude N, Simonsen GS, Löhr IH. APMIS. 2020 Mar;128(3):232-241.
2019:
- Pasteurellaceae. Skaare D. In: Medisinsk mikrobiologi. edn. Edited by Rollag H, Müller F, Tønjum T. Oslo: Gyldendal Akademisk; 2019
- Serological diagnostics of Lyme borreliosis: comparison of assays in twelve clinical laboratories in Northern Europe. Lager M, Dessau RB, Wilhelmsson P, Nyman D, Jensen GF, Matussek A, Lindgren PE, Henningsson AJ; ScandTick Biobank Study Group, Baqir H, Serrander L, Johansson M, Tjernberg I, Skarstein I, Ulvestad E, Grude N, Pedersen AB, Bredberg A, Veflingstad R, Wass L, Aleke J, Nordberg M, Nyberg C, Perander L, Bojesson C, Sjöberg E, Lorentzen ÅR, Eikeland R, Noraas S, Henriksson GA, Petrányi G. Eur J Clin Microbiol Infect Dis. 2019 Oct;38(10):1933-1945.
- En kvinne i 50-årene med kjevesperre og muskelrykninger. Olsen BC, Stubhaug TT, Berild JD. Tidsskr Nor Laegeforen. 2019 Oct 30;139(16).
- Association between antimicrobial resistance among Enterobacteriaceae and burden of environmental bacteria in hospital acquired infections: analysis of clinical studies and national reports. Henriksen TH, Abebe W, Amogne W, Getachew Y, Weedon-Fekjær H, Klein J, Woldeamanuel Y. Heliyon. 2019 Jul 22;5(7):e02054.
2018:
- Predictors of Symptom Duration and Bacteriuria in Uncomplicated Urinary Tract Infection. Bollestad M, Vik I, Grude N, Lindbæk M. Scand J Prim Health Care. 2018 Dec;36(4):446-454.
- Clinical and bacteriological efficacy of pivmecillinam treatment for uncomplicated urinary tract infections caused by ESBL-producing Escherichia coli: a prospective, multicentre, observational cohort study. Bollestad M, Grude N, Solhaug S, Raffelsberger N, Handal N, Nilsen HS, Romstad MR, Emmert A, Tveten Y, Søraas A, Jenum PA, Jenum S, Møller-Stray J, Weme ET, Lindbaek M, Simonsen GS; (the Norwegian ESBL UTI study group). J Antimicrob Chemother. 2018 Sep 1;73(9):2503-2509.
- Ibuprofen versus pivmecillinam for uncomplicated urinary tract infection in women—A double-blind, randomized non-inferiority trial. Vik I, Bollestad M, Grude N, Bærheim A, Damsgaard E, Neumark T, Bjerrum L, Cordoba G, Olsen IC, Lindbæk M. PLoS Med. 2018 May 15;15(5):e1002569.
- A man with laboured breathing, abdominal pain and vomiting. Holmberg M, Krogseth SB, Grude N, Wian KA. Tidsskr Nor Laegeforen. 2018 Mar 19;138(6).
- Species Level Description of the Human Ileal Bacterial Microbiota. Villmones HC, Haug ES, Ulvestad E, Grude N, Stenstad T, Halland A, Kommedal Ø. Sci Rep. 2018 Mar 16;8(1):4736.
2017:
- Betalaktamresistens hos Haemophilus influenzae. Skaare D. Tidsskr Nor Laegeforen. 2017 Mar 21;137(6):471.
- The spread and clinical impact of ST14CC-PBP3 type IIb/A, a clonal group of non-typeable Haemophilus influenzae with chromosomally mediated β-lactam resistance-a prospective observational study. Månsson V, Skaare D, Riesbeck K, Resman F. Clin Microbiol Infect. 2017 Mar;23(3):209.e1-209.e7.
- Chlamydia testing in practice - requisitioners and patients. Romoren M, Skaare D, Grude N. Tidsskr Nor Laegeforen 2017, 137(19).
- Bacteriology in uncomplicated urinary tract infections in Norwegian general practice from 2001-2015. Bollestad M, Vik I, Grude N, Blix HS, Brekke H, Lindbaek M. BJGP Open. 2017 Oct 4;1(4):bjgpopen17X101145.
- Blood donor Borrelia burgdorferi sensu lato seroprevalence and history of tick bites at a northern limit of the vector distribution. Hvidsten D, Mortensen L, Straume B, Arsenovic MG, Pedersen AB, Lyngås G, Gray JS, Grude N. APMIS. 2017 Aug;125(8):717-724.
- Norwegian patients and retail chicken meat share cephalosporin-resistant Escherichia coli and IncK/blaCMY-2 resistance plasmids. Berg ES, Wester AL, Ahrenfeldt J, Mo SS, Slettemeås JS, Steinbakk M, Samuelsen Ø, Grude N, Simonsen GS, Løhr IH, Jørgensen SB, Tofteland S, Lund O, Dahle UR, Sunde M. Clin Microbiol Infect. 2017 Jun;23(6):407.e9-407.e15.
- Atypisk optikusnevritt. Sand MK, Stubhaug TT, Jørstad ØK. Tidsskr Nor Laegeforen. 2017 May 23;137(10):731.
- Incidence and antibiotic treatment of erythema migrans in Norway 2005–2009. Eliassen KE, Berild D, Reiso H, Grude N, Christophersen KS, Finckenhagen C, Lindbæk M. Ticks Tick Borne Dis. 2017 Jan;8(1):1-8.
2016:
- Fatal primary amoebic meningoencephalitis in a Norwegian tourist returning from Thailand. Stubhaug TT, Reiakvam OM, Stensvold CR, Hermansen NO, Holberg-Petersen M, Antal EA, Gaustad K, Førde IS, Heger B. JMM Case Rep. 2016(3) [nettpubl.]
- Identification of a novel IMI carbapenemase variant (IMI-9) in Enterobacter cloacae complex. Di Luca MC, Skaare D, Aasnaes B, Sundsfjord A, Samuelsen Ø. Int J Antimicrob Agents. 2016 Dec;48(6):764-765.
- Non-beta lactamase-mediated beta-lactam resistance in Haemophilus influenzae: mechanisms, epidemiology and susceptibility testing. Skaare D. Doctoral thesis. Tromsø: UiT; 2016
- Prevalence of M. genitalium and U. urealyticum in urine tested for C. trachomatis. Paulsen LK, Dahl ML, Skaare D, Grude N. Tidsskr Nor Laegeforen 2016, 136(2):121-125.
2015:
- Haemophilus influenzae with Non-Beta-Lactamase-Mediated Beta-Lactam Resistance: Easy To Find but Hard To Categorize. Skaare D, Lia A, Hannisdal A, Tveten Y, Matuschek E, Kahlmeter G, Kristiansen BE. J Clin Microbiol. 2015 Nov;53(11):3589-95.
- Antibiotic prescriptions and cycles of Mycoplasma pneumoniae infections in Norway: can a nationwide prescription register be used for surveillance? Blix HS, Vestrheim DF, Hjellvik V, Skaare D, Christensen A, Steinbakk M. Epidemiol Infect 2015, 143(9):1884-1892.
- Twenty-two years of candidaemia surveillance: results from a Norwegian national study. Hesstvedt L, Gaustad P, Andersen CT, Haarr E, Hannula R, Haukland HH, Hermansen NO, Larssen KW, Mylvaganam H, Ranheim TE, Sandven P, Nordøy I; Norwegian Yeast Study Group, Kanestrøm A, Grub C, Onken A, Thielsen C, Skaare D, Tofteland S, Sønsteby LJ, Hjetland R, Hide R, Vik E, Kümmel A, Åsheim S. Clin Microbiol Infect. 2015 Oct;21(10):938-45.
- Antibiotic resistance patterns of bacteria causing urinary tract infections in the elderly living in nursing homes versus the elderly living at home: an observational study. Fagan M, Lindbæk M, Grude N, Reiso H, Romøren M, Skaare D, Berild D. BMC Geriatr. 2015 Aug 4;15:98.
- Mycoplasma pneumoniae detection causes excess antibiotic use in Norwegian general practice: a retrospective case-control study. Foshaug M, Vandbakk-Ruther M, Skaare D, Grude N, Lindbaek M. Br J Gen Pract 2015, 65(631):e82-88.
- Subjective health complaints are not associated with tick bites or antibodies to Borrelia burgdorferi sensu lato in blood donors in western Norway: a cross-sectional study. Hjetland R, Reiso H, Ihlebæk C, Nilsen RM, Grude N, Ulvestad E. BMC Public Health. 2015 Jul 14;15:657.
- A randomized controlled trial of a diagnostic algorithm for symptoms of uncomplicated cystitis at an out-of-hours service. Bollestad M, Grude N, Lindbaek M. Scand J Prim Health Care. 2015 Jun;33(2):57-64.
- Symptomatic and asymptomatic secondary transmission of Cryptosporidium parvum following two related outbreaks in schoolchildren. Johansen OH, Hanevik K, Thrana F, Carlson A, Stachurska-Hagen T, Skaare D, Robertson LJ: Epidemiol Infect 2015, 143(8):1702-1709.
- High Mortality from Blood Stream Infection in Addis Ababa, Ethiopia, Is Due to Antimicrobial Resistance. Seboxa T, Amogne W, Abebe W, Tsegaye T, Azazh A, Hailu W, Fufa K, Grude N, Henriksen TH. PLoS One. 2015 Dec 15;10(12):e0144944.
- International collaboration in postgraduate training. Engjom HM, Henriksen TH, Young S, Hansen KS. Tidsskr Nor Laegeforen. 2015 Oct 6;135(18):1662-5. doi: 10.4045/tidsskr.14.0895. eCollection 2015 Oct 6.
2014:
- Emergence of clonally related multidrug resistant Haemophilus influenzae with penicillin-binding protein 3-mediated resistance to extended-spectrum cephalosporins, Norway, 2006 to 2013. Skaare D, Anthonisen IL, Kahlmeter G, Matuschek E, Natås OB, Steinbakk M, Sundsfjord A, Kristiansen BE. Euro Surveill. 2014 Dec 11;19(49):20986.
- Multilocus sequence typing and ftsI sequencing: a powerful tool for surveillance of penicillin-binding protein 3-mediated beta-lactam resistance in nontypeable Haemophilus influenzae. Skaare D, Anthonisen IL, Caugant DA, Jenkins A, Steinbakk M, Strand L, Sundsfjord A, Tveten Y, Kristiansen BE. BMC Microbiol. 2014 May 20;14:131.
- Ibuprofen versus mecillinam for uncomplicated cystitis - a randomized controlled trial study protocol. Vik I, Bollestad M, Grude N, Bærheim A, Mölstad S, Bjerrum L, Lindbæk M. BMC Infect Dis. 2014 Dec 17;14:693.
- Seroprevalence of antibodies to tick-borne encephalitis virus and Anaplasma phagocytophilum in healthy adults from western Norway. Hjetland R, Henningsson AJ, Vainio K, Dudman SG, Grude N, Ulvestad E. Infect Dis (Lond). 2015 Jan;47(1):52-6.
- Black chokeberry juice (Aronia melanocarpa) reduces incidences of urinary tract infection among nursing home residents in the long term--a pilot study. Handeland M, Grude N, Torp T, Slimestad R.Nutr Res. 2014 Jun;34(6):518-25.
- High levels of multiresistance in quinolone resistant urinary tract isolates of Escherichia coli from Norway; a non clonal phenomen? Strand L, Jenkins A, Henriksen IH, Allum AG, Grude N, Kristiansen BE.BMC Res Notes. 2014 Jun 19;7:376.
- Seroprevalence of antibodies to Borrelia burgdorferi sensu lato in healthy adults from western Norway: risk factors and methodological aspects. Hjetland R, Nilsen RM, Grude N, Ulvestad E.APMIS. 2014 Nov;122(11):1114-24.
- Borreliose og forlegenhet. Henriksen TH. Tidsskr Nor Laegeforen. 2014 Jan 28;134(2):138.
- Second outbreak of infection with a rare Cryptosporidium parvum genotype in schoolchildren associated with contact with lambs/goat kids at a holiday farm in Norway. Lange H, Johansen OH, Vold L, Robertson LJ, Anthonisen IL, Nygard K. Epidemiol Infect. 2014 Oct;142(10):2105-13.
2013:
- New guidelines for use of antibiotics in the primary health care service. Lindbæk M, Jensen S, Eliassen KE, Fetveit A, Grude N, Berild D, Hjortdahl P.Tidsskr Nor Laegeforen. 2013 May 28;133(10):1052-3.
- Tick bites in healthy adults from western Norway: occurrence, risk factors, and outcomes. Hjetland R, Eliassen KE, Lindbæk M, Nilsen RM, Grude N, Ulvestad E.Ticks Tick Borne Dis. 2013 Jun;4(4):304-10.
2012:
- Recovery of Bordetella pertussis from PCR-positive nasopharyngeal samples is dependent on bacterial load. Vestrheim DF, Steinbakk M, Bjørnstad ML, Moghaddam A, Reinton N, Dahl ML, Grude N, Sandven P.J Clin Microbiol. 2012 Dec;50(12):4114-5.
2011:
- Hvordan stoppe multiresistente bakterier? Tveten Y, Sarjomaa MA, Skaare D, Grude N, Samuelsen Ø. Tidsskr Nor Laegeforen. 2011 Apr 8;131(7):698-700.
2010:
- Mutant ftsI genes in the emergence of penicillin-binding protein-mediated beta-lactam resistance in Haemophilus influenzae in Norway. Skaare D, Allum AG, Anthonisen IL, Jenkins A, Lia A, Strand L, Tveten Y, Kristiansen BE. Clin Microbiol Infect. 2010 Aug;16(8):1117-24.
Vi har forskningssamarbeid med blant andre Folkehelseinstituttet, Nasjonal kompetansetjeneste for påvisning av antibiotikaresistens (K-res), Antibiotikasenteret for primærmedisin (ASP), Norges Arktiske Universitet UIT, Universitetet i Oslo, OsloMet, Oslo Universitetssykehus, Universitetet i Agder og Sykehuset i Telemark.
Utenlandske samarbeidspartnere inkluderer blant andre Nordic Committee on Antimicrobial Susceptibility Testing (NordicAST), European Committee on Antimicrobial Susceptibility Testing (EUCAST), Karolinska Institutet og Karolinska Universitetssjukhuset, Odense Universitetshospital, McGill University Health Centre (Canada), Yekatit 12 Hospital Medical College, Tikur Anbessa Specialized Hospital /Addis Ababa University (Etiopia), Folkhälsomyndigheten i Sverige (Public Health Agency of Sweden) og Statens Serum Institut i Danmark (Statens Serum Institut).
- Helse Sør-Øst RHF
- Sykehuset i Vestfold HF
- Sykehuset i Vestfold HF og Sykehuset Telemark HF (samarbeidsmidler)
- Norsk overvåkingssystem for antibiotikaresistens hos mikrober (NORM)
- OsloMet – Storbyuniversitetet
- Turning the Tide of Antimicrobial resistance (TTA, forskningsnettverk i HSØ)
- Norsk forening for medisinsk mikrobiologi (NFMM)
- Nordic Committee on Antimicrobial Susceptibility Testing (NordicAST)
- Scandinavian Society for Antimicrobial Agents and Chemotherapy (SSAC)
- Norsk forskningsråd (via the EU Joint Programming Initiative on Antimicrobial Resistance – JPIAMR)
Hyppige urinveisinfeksjoner betyr mange antibiotikakurer. Men det finnes et alternativ. – Aftenposten
Studie: Legemiddel som ikke gir resistens, forebygger urinveisinfeksjoner hos eldre - Dagens Medisin
Antibiotikaresistens– NRK Vestfold og Telemark
Nå må vi ta enterokokkene på alvor - Dagens medisin
«Advarer mot antibiotikaresistens» – NRK.no
«Advarer på det sterkeste mot overdreven antibiotikabruk» – TB.no
«ImpresU - Forbedre håndteringen av urinveisinfeksjoner (UVI) hos eldre» – UiO.no
«Lokal "indianermedisin" tas til ny fase, testes på unge kvinner» – Aftenbladet.no
«Forsker på aroniabærs effekt på immunforsvaret» – Nationen.no
«Den nye maskinen får avdelingsoverlege Dagfinn til å smile: – Gir håp for fremtiden» – TB.no
«Vil isolere personer som mister smaks- og luktesansen» – dagensmedisin.no
«Fikk eksklusiv plass på ny forskerlinje» – bioingenioren.no